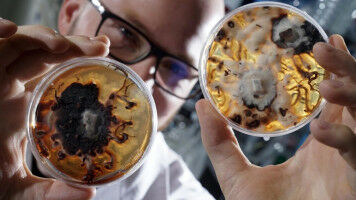
Wiedergeburt einer Sammlung

news
Friedrich-Schiller-Universität Jena
Ergebnisse 301 - 306 von 306.
Biowissenschaften - Gesundheit - 22.11.2018

Wasserstoff und Naturstoffe werden von mehr Bakterien produziert als bisher bekannt Es gibt Bakterien, die Wasserstoff und Naturstoffe produzieren, was sowohl für die Umwelt als auch für die Medizin wichtig ist. In Jena hat ein Forschungsteam nun die Fähigkeit zur Wasserstoffund Naturstoffproduktion in einer Gruppe von Bakterien nachgewiesen, die bis dahin eher als Krankheitserreger bekannt waren.
Biowissenschaften - 09.11.2018
Pharmazeuten entdecken bisher unbekannte Prozesse in Immunzellen bei der Bildung entzündlicher Botenstoffe und öffnen so Türen für neue Behandlungsstrategien von Entzündungen Zur Abwehr von Fremdkörpern, etwa Mikroorganismen, ist der Mensch mit einem effektiven System ausgestattet. Immunzellen senden Botenstoffe, wie zum Beispiel Leukotriene aus, die das körpereigene Abwehrsystem in Gang setzen.
Chemie - Umwelt - 01.11.2018

Chemiker der Universität Jena entdecken bisher unbekannten Stoffwechselweg im Plankton Schwefel findet sich in ganz unterschiedlichen Verbindungen überall auf der Erde: sowohl in der Atmosphäre als auch in den Weltmeeren und an Land. All diese Erscheinungsformen sind in einem Kreislauf miteinander verbunden.
Biowissenschaften - Umwelt - 15.10.2018

Neue Studie in Biodiversitäts-Hotspot hat den Zusammenhang zwischen der Größe von tropischen Schmetterlingen und ihrer Höhenverbreitung untersucht Mehr als 19. Falter von 1. Arten haben Jenaer Wissenschaftler zusammen mit Kollegen aus Marburg und Connecticut/USA vermessen. Sie wollten herausfinden, ob sich die Größe von tropischen Schmetterlingen mit der Meereshöhe ändert.
Biowissenschaften - Psychologie - 12.10.2018

Psychologen entwickeln Training zur Verbesserung des Gesichtsgedächtnisses " Der kommt mir bekannt vor - aber woher? " Nicht selten schießt das vor allem älteren Menschen durch den Kopf, wenn sie einer anderen Person begegnen. Denn wenn im Alter das Gedächtnis nachlässt, dann leidet auch die Gesichtserkennung.
Pharmakologie - Gesundheit - 04.10.2018
Durch Karikaturen Gesichter erkennen
Pharmazeuten und Biochemiker der Universität Jena entschlüsseln mit internationalem Forscherteam die entzündungshemmende Wirkungsweise von Vitamin E und seiner Stoffwechselprodukte. Das Ergebnis zeigt Nutzen einer personalisierten Medizin auf. Der patentierte Wirkstoffkandidat wird nun weiter erforscht.











